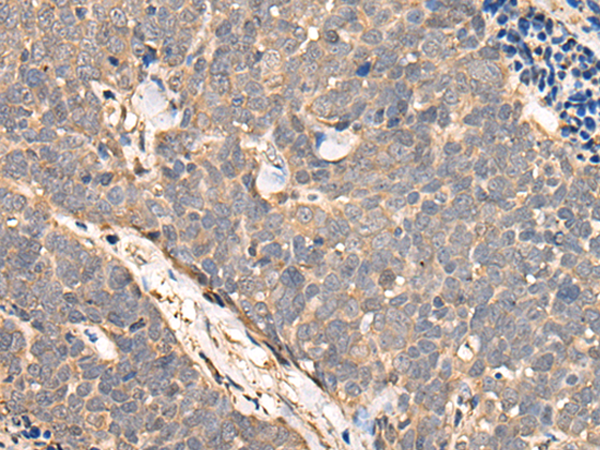

中文名稱 : 兔抗NCAPH多克隆抗體
英文名稱 : Anti-NCAPH rabbit polyclonal antibody
別 名 : BRRN1; CAP-H
儲 存 : 冷凍(-20℃)
抗 原 : NCAPH
宿 主 : Rabbit
反應(yīng)種屬 : Human, Mouse
相關(guān)類別 : 一抗
標 記 物 : Unconjugate
克隆類型 : rabbit polyclonal
技術(shù)規(guī)格
|
Background: |
This gene encodes a member of the barr gene family and a regulatory subunit of the condensin complex. This complex is required for the conversion of interphase chromatin into condensed chromosomes. The protein encoded by this gene is associated with mitotic chromosomes, except during the early phase of chromosome condensation. During interphase, the protein has a distinct punctate nucleolar localization. Alternatively spliced transcript variants encoding different proteins have been described. |
|
Applications: |
ELISA, IHC |
|
Name of antibody: |
NCAPH |
|
Immunogen: |
Fusion protein of human NCAPH |
|
Full name: |
non-SMC condensin I complex subunit H |
|
Synonyms: |
BRRN1; CAP-H |
|
SwissProt: |
Q15003 |
|
ELISA Recommended dilution: |
5000-10000 |
|
IHC positive control: |
Human cervical cancer |
|
IHC Recommend dilution: |
25-100 |

購物車
幫助
021-54845833/15800441009
